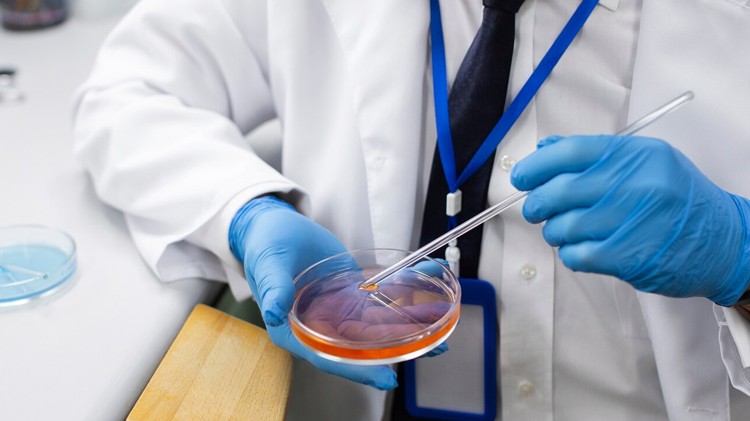
#

Our Active Campaigns
Loading campaigns...

About
Global Vision
We, Global Vision Cancer NGO proudly introduce ourselves as India's pioneer NGO focussing on eradicating cancer. With an aim of helping needy cancer patients and mission of Cancer Free India, in the last 7 years Global Vision has donated Rs. 8 Crore to 3200 needy cancer patients in the form ofmedicinal assistance and financial aid. We have organized 210 medical camps in which approx. 21000 people have been screened for cancer and have conducted seminars for more than a thousand people in Slums, Corporates, Residential Complexes etc.
What We Do
Prevent Cancer
Seminars & News Bulletins
Diagnose Cancer
Detection Camps
Treat Cancer
Financial & Medicinal Help
News & Media
Global Vision Is Supported By
Recent Articles
Oral Cancer In India
Oral cancer is a major public health problem in the Indian subcontinent, where it ranks among the to...
Myfirstblog
Oral cancer is a major public health problem in the Indian subcontinent, where it ranks among the to...
Media Coverage
Our Hospitals by City

Mumbai

Pune

Surat

Bangalore
Delhi

Hydrabad

Lucknow

Ahmedabad

Solapur

Kolhapur

Mangalore